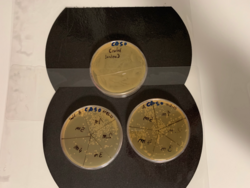
Ergebnis und Auswertung der Inaktivierung

Entwicklung eines mobilen Luft-Kalt-Plasma-Gerätes für medizinische Applikationen
Laufzeit: 10.10.2023 - 20.02.2024
Kurzfassung
Im Rahmen meiner Masterarbeit widmete ich mich der Entwicklung eines innovativen Geräts auf Basis der Plasma-Technologie für medizinische Anwendungen. Diese interdisziplinäre Aufgabe erforderte fundierte Kenntnisse in Medizin, Plasmaphysik, Informatik und Elektrotechnik. Ziel war die Konstruktion eines multifunktionalen Plasma-Geräts, das über modernste Technologie gesteuert und überwacht werden kann.
Das Gerät zeichnet sich durch eine Bluetooth-Schnittstelle aus, die eine einfache Verbindung...Im Rahmen meiner Masterarbeit widmete ich mich der Entwicklung eines innovativen Geräts auf Basis der Plasma-Technologie für medizinische Anwendungen. Diese interdisziplinäre Aufgabe erforderte fundierte Kenntnisse in Medizin, Plasmaphysik, Informatik und Elektrotechnik. Ziel war die Konstruktion eines multifunktionalen Plasma-Geräts, das über modernste Technologie gesteuert und überwacht werden kann.
Das Gerät zeichnet sich durch eine Bluetooth-Schnittstelle aus, die eine einfache Verbindung mit einem Smartphone ermöglicht. Dadurch können alle Parameter bequem gesteuert und überwacht werden, was die Benutzerfreundlichkeit erheblich steigert.
Entwicklungsschritte
- PCB-Design: Entwurf und Entwicklung einer Leiterplatte zur Steuerung des Plasmas sowie eines Luftkompressors.
- C-Programmierung: Erstellung von Software zur Überwachung und Steuerung des Geräts, einschließlich:
- Distanzmessung zur Positionierung.
- Anzeige des Batteriestatus.
- Steuerung des Luftstroms.
- Messung der Anwendungsdauer.
- Gerätekonstruktion: Design und Zusammenbau aller mechanischen und elektronischen Komponenten zu einem funktionalen Endgerät.
Testphase und Validierung
Nach der Fertigstellung des Geräts wurden umfangreiche Tests durchgeführt:
1. Spektroskopische Analyse: Untersuchung der ionisierten Bestandteile der Luft, um die chemische Zusammensetzung des Plasmas zu bestimmen. Insbesondere wurde das Potenzial zur Generierung von Stickstoffmonoxid (NO) nachgewiesen, das für medizinische Anwendungen, wie die Förderung der Wundheilung, von großer Bedeutung ist.
2. Mikrobiologische Tests: Das Gerät wurde auf die Inaktivierung von *E. coli*-Bakterien getestet. Die Ergebnisse zeigten, dass das Plasma eine signifikante antibakterielle Wirkung besitzt. Der Durchmesser des Hemmhofs wuchs proportional zur Anwendungsdauer, was die Effektivität des Geräts unterstreicht.
Ergebnisse
Das Ergebnis war ein vollständig funktionales und multifunktionales Plasma-Gerät mit folgenden Eigenschaften:
- Antibakterielle Wirkung: Erfolgreiche Inaktivierung von *E. coli*-Bakterien durch Kaltplasma.
- Medizinisches Potenzial: Generierung von Stickstoffmonoxid, das vielseitig in der Therapie einsetzbar ist.
- Benutzerfreundlichkeit: Smartphone-Konnektivität und präzise Steuerung der Anwendungsparameter.
Diese Arbeit stellt einen bedeutenden Beitrag zur Weiterentwicklung der Plasma-Technologie im medizinischen Bereich dar und bietet Potenzial für weitere Forschungs- und Anwendungsgebiete.» weiterlesen» einklappen